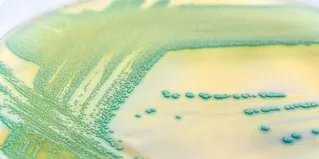
欧莱雅惊绽浓密睫毛膏

第一步: 滋养定位
银色膏体精华配方含膜状聚合物,给每一根睫毛裹上保护膜, 还有维他命原B5深层滋养睫毛,为下一步打底.高精确定位的基础刷头梳理每一根睫毛,使其完美卷翘,纤长,并根根分明。
第二步: 浓密分明
瞬间浓密配方使光滑膏体从根部至尖部完美包裹丰盈睫毛,蜡离散剂使膏体更具延展性更易上妆。纯黑微粉色素塑造超浓黑非凡妆效。精确刷头确保膏体迅速包裹睫毛。且无粘连。根根分明!
(实习编辑:胡丹)

第一步: 滋养定位
银色膏体精华配方含膜状聚合物,给每一根睫毛裹上保护膜, 还有维他命原B5深层滋养睫毛,为下一步打底.高精确定位的基础刷头梳理每一根睫毛,使其完美卷翘,纤长,并根根分明。
第二步: 浓密分明
瞬间浓密配方使光滑膏体从根部至尖部完美包裹丰盈睫毛,蜡离散剂使膏体更具延展性更易上妆。纯黑微粉色素塑造超浓黑非凡妆效。精确刷头确保膏体迅速包裹睫毛。且无粘连。根根分明!
(实习编辑:胡丹)